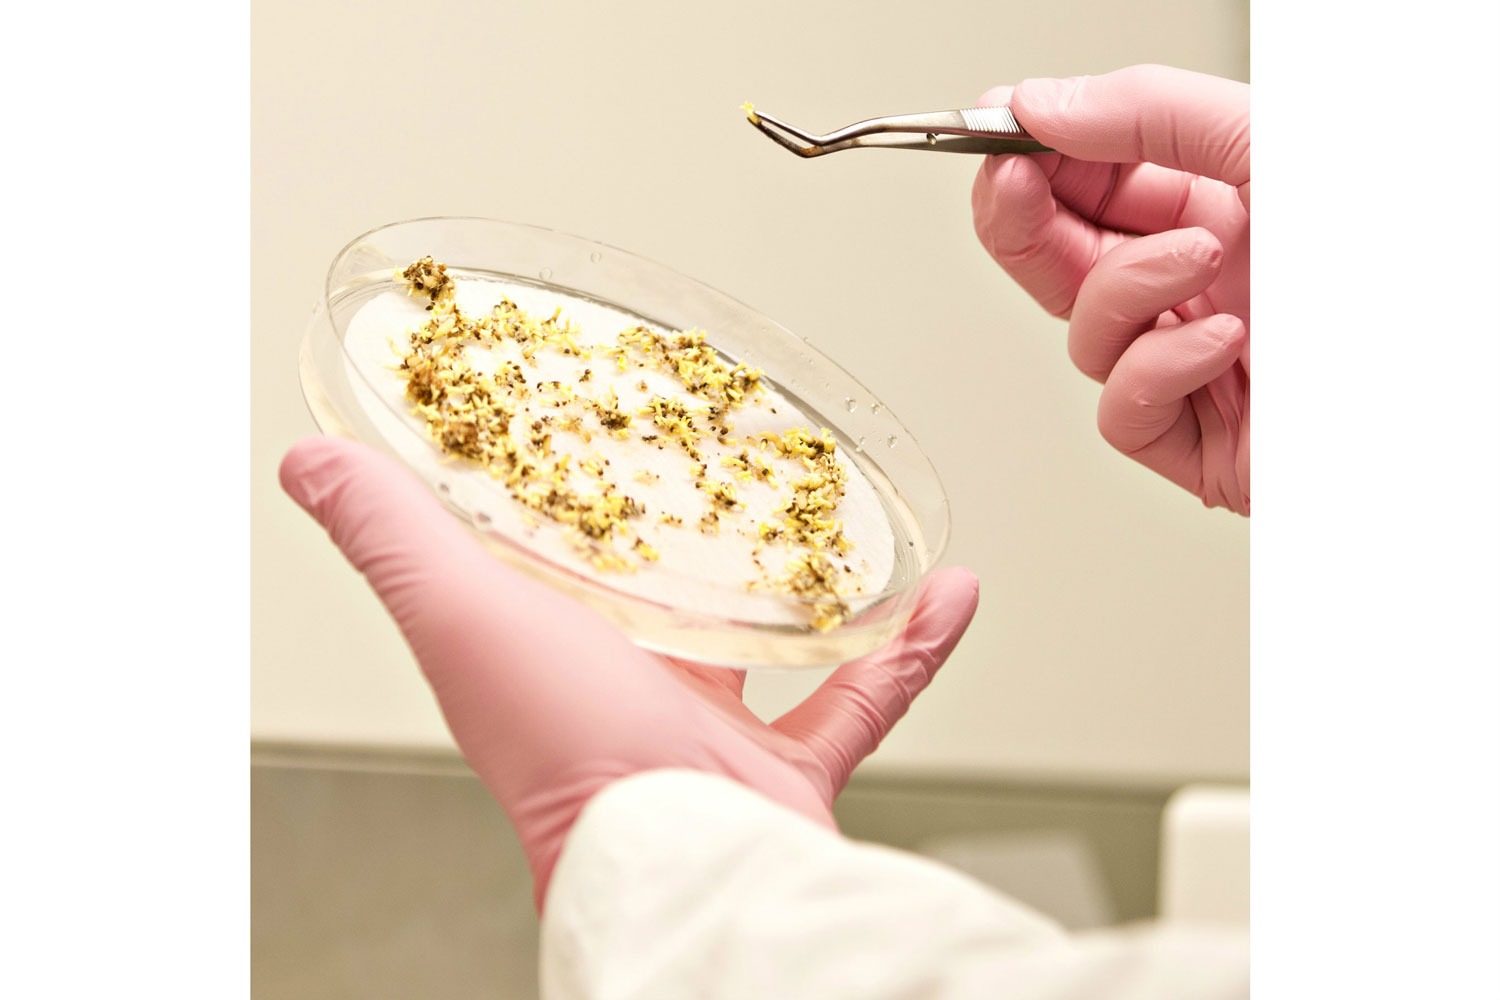
2

Automated Somatic Embryogenesis
Automated Somatic Embryogenesis
Automated in vitro Somatic Embryogenesis (SE) technology for large-scale production of elite plant material.
Somatic embryogenesis (SE) in conifers was discovered in the mid 1980s and is a method of vegetative propagation, where from a single seed one can produce large numbers of plants.
SweTree is developing a highly automated and cost-efficient method for producing large numbers of plants via SE. This will enable more efficient use and deployment of elite plant material. The species in focus today is spruce (Picea), but this technology could prove a good alternative for many different crops like sugar cane and potatoe as well as trees like pine (Pinus).
SweTree is now setting up a pilot facility for SE spruce (Picea abies) plants that will be fully up and running in February 2021. SweTree´s solution contains state of the art robotics and Articifical Intelligens (AI). Next step, after the pilot phase, (2022/2023) is to start building a full-scale factory with the capacity of 20 million plants per year with SweTree’s Swedish customers Stora Enso, Sveaskog, Södra and Holmen.
Together with UPSC and selected partners, SweTree is also developing the use of Genomic Selection (GS) in combination with large-scale SE spruce production. When combining SE and GS, SweTree envision an increase of growth of more than 30% as well as a reduction of root rot of more than 50% in spruce.
Short movie introducing SweTree´s SE-automation process.